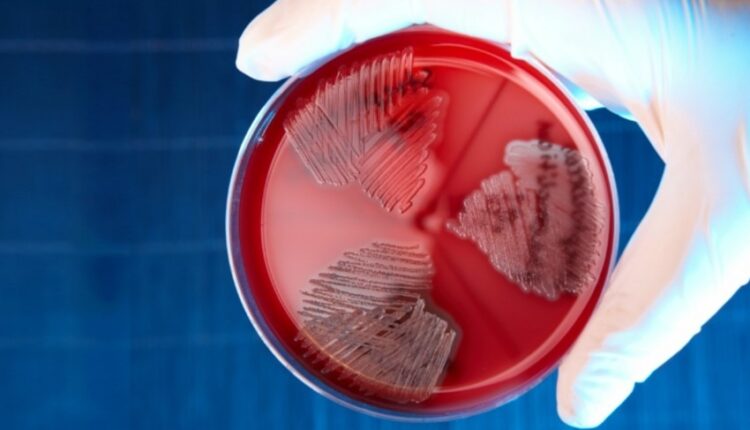

Honq-Konqda 27 nəfər streptokok infeksiyasına yoluxub, onlardan ikisi ölüb.
Bu barədə “South China Morning Post” qəzeti məlumat yayıb.
Son bir neçə həftə ərzində Honq-Konqda streptokok infeksiyasının epidemiyası qeydə alınıb.
Xəstələr arasında 53 yaşdan 88 yaşa qədər 10 kişi və 17 qadın var.
Qəzetin qeyd etdiyi kimi, yoluxmuş beş nəfər artıq tibb müəssisələrindən evə buraxılıb, 17 xəstənin vəziyyəti stabildir, daha 3 nəfərin vəziyyəti ağırdır.
Xəstəliyin simptomları sepsis, oynaqların absesi, meningit və sidik yollarının iltihabı hesab olunur.
İnfeksiya mənbəyi şirin su balığıdır. Epidemioloqlar sakinləri müvəqqəti olaraq su balığı yeməkdən çəkinməyə, həmçinin əllərində açıq yaralar varsa, onu təmizləməməyə çağırıb.//Report

Comments are closed.